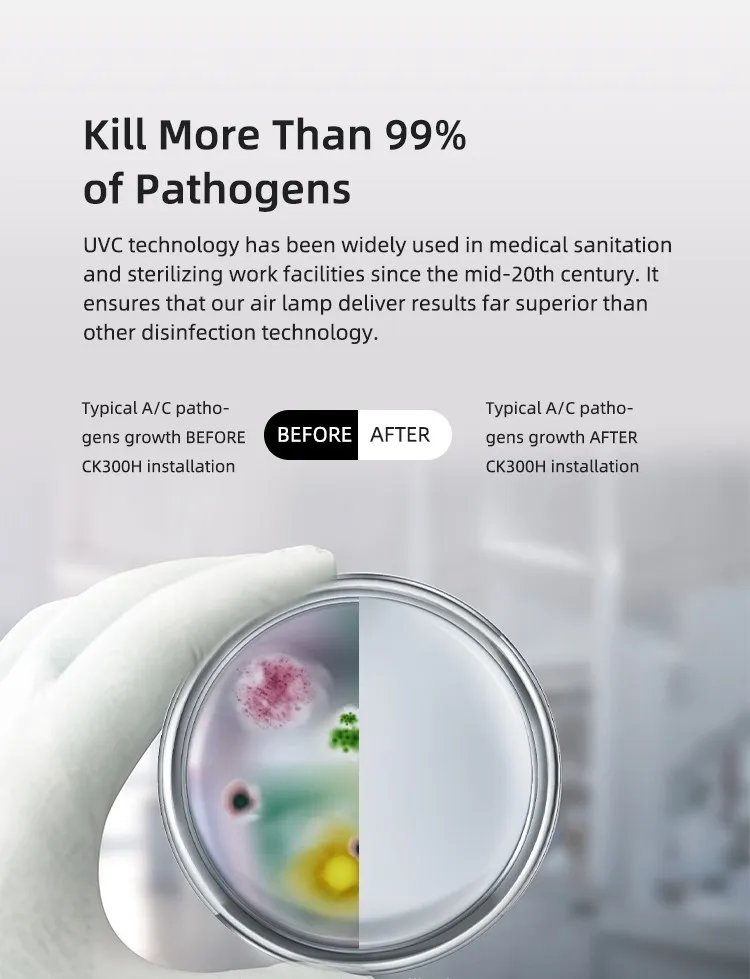
Feature Graphic 2

35W Air Handler HVAC System UV Sanitizing Lamp Kit for Ceiling Cassette A/C Systems
Product Description
Basic Information
Product Overview
35W Air Handler HVAC System UV Sanitizing Lamp Kit for Ceiling Cassette A/C Systems

Mini UV LED is a pioneering UV light system specifically designed for cassette and limited space applications. It prevents internal mold growth and microbial contamination on blower wheels without impacting plastic materials.
Product Parameters
| ITEM | VOLTAGE | POWER | CONTROLLER | REMARK |
|---|---|---|---|---|
| CK30E | 100-240V | 35W | Airflow Sensor | Cassette 335mm*2 UV Lamp |
| Technical Specifications | Value / Detail | ||
|---|---|---|---|
| Product Name | Germicidal UV-C Lamp | Rated Power | 35W |
| Input Voltage | 90-264V | UV Maintenance | 100-8000H:≥80% |
| Wavelength | 253.7nm | UV Optical Power | ≥50000μw/cm² |
| Application Area | ≤60m³ | Antibacterial Rate | 90%-100% |
Key Benefits & Features
- ✔️ Maintains clean cassette system
- ✔️ Fights mold on blower wheel
- ✔️ Reduces maintenance costs
- ✔️ Improves indoor air quality
- ✔️ 35W High Power disinfection
- ✔️ Intelligent Airflow Control
- ✔️ 12,000 Hours long lifetime
- ✔️ Plug-and-Play operation
Detailed Features
Working Principle
Utilizes ultraviolet light and photocatalytic oxidation (PCO) technology for whole-house purification. Effectively breaks down VOCs, bacteria, and allergens into harmless water and CO2.

High-Transmission Quartz Tube
Ensures efficient UV transmission and maximizes photocatalytic reaction performance.

Intelligent Airflow Sensor
Automatically activates or deactivates purification based on real-time airflow, ensuring energy-efficient operation.

Installations & Dimensions


Application Areas
Provides maximum UVC germicidal disinfection for ductless units in:
- HVAC Systems & Mini-splits
- Hotels, Motels & Apartments
- Hospitals & Medical Offices
- Schools & Kindergartens
- Offices, Malls & Cinemas
- Gyms & Residential Homes

Packaging & Shipping

 Dextra Light
Dextra Light









